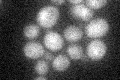
YER167W
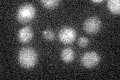
YER167W

View description
Protein rich in serine and threonine residues involved in protein kinase C signaling pathway, which controls cell integrity; overproduction suppresses pkc1 mutations
Localization:
Intensity:
Fold change:
Significance:
-
C’ GFP library in SD
nucleus:cytosol18.61 -
N' NOP1pr-GFP in SD

cytosol,nucleus32.742 -
N' TEF2pr-mCherry in SD

nucleus18.686 -
N' NATIVEpr-GFP in SD

ambiguous,nucleus20.3519 -
N' TEF2pr-VC and Cyto-VN in SD

below threshold19.834 -
C’ GFP library in SD+DTT

nucleus.cytosol24.131.29No -
C’ GFP library in SD+H2O2

nucleus.cytosol19.521.04No -
C’ GFP library in Starvation Media
nucleus,cytosol18.631No -
C’ GFP library on the background of Pup2-DaMP

nucleus:cytosol -
C’ GFP library on the background of CCT mutant

nucleus:cytosol19.69041.05745No
